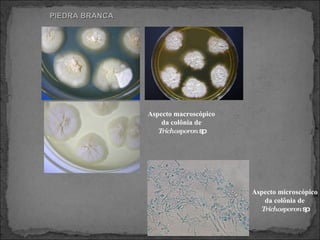
PIEDRA BRANCA Aspecto macroscópico da colônia de  Trichosporon  sp Aspecto microscópico da colônia de  Trichosporon  sp

O documento discute vários tipos de infecções fúngicas da pele, incluindo pityriase versicolor, piedra branca, piedra negra, tineas e onicomicose. Ele fornece informações sobre o agente etiológico, epidemiologia, manifestações clínicas, diagnóstico e tratamento de cada uma dessas condições.